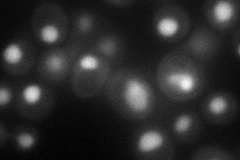
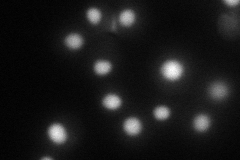
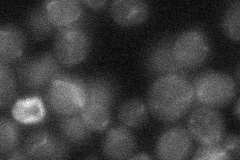
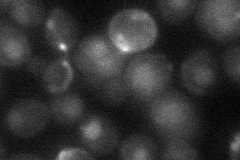
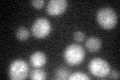
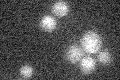

View description
Meiosis-specific serine/threonine protein kinase, functions in meiotic checkpoint, promotes recombination between homologous chromosomes by suppressing double strand break repair between sister chromatids
Localization:
Intensity:
Fold change:
Significance:
-
C’ GFP library in SD

below threshold16 -
N' NOP1pr-GFP in SD
nucleus57.1484 -
N' TEF2pr-mCherry in SD
nucleus44.4045 -
N' NATIVEpr-GFP in SD
below threshold19.3059 -
N' TEF2pr-VC and Cyto-VN in SD
nucleus32.2247 -
C’ GFP library in SD+DTT
cytosol17.451.09No -
C’ GFP library in SD+H2O2

cytosol14.320.89No -
C’ GFP library in Starvation Media
cytosol13.710.85No -
C’ GFP library on the background of Pup2-DaMP

below threshold -
C’ GFP library on the background of CCT mutant

below threshold17.81581.11321No
